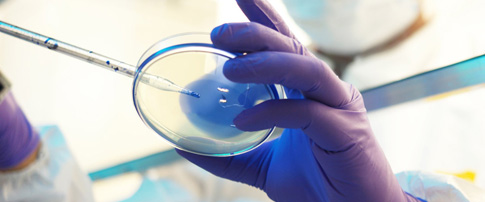

MALDI-TOF MS System
Application
MALDI-TOF MS (Matrix Assisted Laser Desorption/Ionization Time-of-Flight Mass Spectrometry) has been used more and more widely in microbiological clinical laboratory for the identification of pathogenic bacteria, especially microaerobes, anaerobes, mycobacteria and fungi with its its powerful database and excellent performance.

Pharmaceutical Microbiology

Veterinary Microbiology

Water Testing Microbiology

Food & Beverage Microbiology

Microbiological Research
Microbiology & Diagnostics
Features
Database
1. Complete database of more than 16,000 strains covering more than 5000 species and 1000 genera . Marine microorganisms (>1000 species)
2. Unique filamentous fungi database of more than 1000 strains covering 450 +species and 70+ genera.
3. Various database of quality control strains from clinical, food and drug, disease control and other fields.
4. Localized and updatable microbial strain database with high identification accuracy.
Hardware
1. High power turbine-molecular pump realizes the simulatanous tests once slide loaded.
2. Innovative optical shaping system greatly improve the quality of the spectrum.
3. Vacuum multivariate identification control algorithm can greatly prolong the life of molecular pump and shorten the waiting time for target entry.
4. Unique design of signal detection system guarantees identification results within 0.1 seconds.
5. Ultra-low noise ion detectors achieve extremely low spectral baselines.
6. Solid state lasers can be used billions of times.
7. separated metal target plate, reduce the risk of pollution.
Specification

Operation Procedure

Request a Quote

